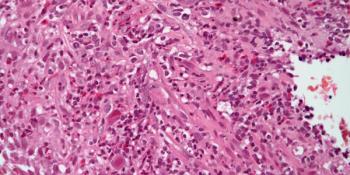

A 54-year-old man presents with dyspnea and chest pain. An intrapulmonary mass is found. What is your diagnosis?

Your AI-Trained Oncology Knowledge Connection!


A 54-year-old man presents with dyspnea and chest pain. An intrapulmonary mass is found. What is your diagnosis?

A 54-year-old woman is found to have a skin lesion on her right arm, and a biopsy is performed. What is your diagnosis?

A 57-year-old man presents with a mass in the right shoulder. After a biopsy is performed, what is your diagnosis?

A 5-month-old boy is found to have a kidney tumor, and a biopsy is performed. What is your diagnosis?
.PNG?w=350&fit=crop&auto=format)
A 38-year-old woman with a history of hyperparathyroidism presents with a lesion in the left humerus bone. What is your diagnosis?

A 42-year-old woman presents with a breast mass, and a biopsy is performed. What is your diagnosis?

A 43-year-old woman presents with vaginal bleeding, and an endocervical biopsy is performed. What is you diagnosis?

A 60-year-old man with a history of chronic obstructive pulmonary disease presents with pain in the left side of his abdomen. What is your diagnosis?

A 47-year-old woman presents with a mass in her right calf, and a biopsy is performed. What is your diagnosis?
.PNG?w=350&fit=crop&auto=format)
A 27-year-old man presents with a lesion in the right scapular region. What is your diagnosis?

A 32-year-old man presents with a mass on his left thigh, and a biopsy is performed. What is your diagnosis?

A 48-year-old man presents with diffuse pulmonary infiltrates, and a biopsy is performed. What is your diagnosis?
.PNG?w=350&fit=crop&auto=format)
A 34-year-old woman presents with a lesion in the right neck. After the biopsy, what is your diagnosis?

A 38-year-old man presents with a right shoulder mass, and a biopsy is performed. What is your diagnosis?

A 58-year-old man presents with a skin lesion, and a biopsy is performed. What is your diagnosis?

A 37-year-old woman is found to have an enlarged thyroid gland, and a biopsy is performed. What is your diagnosis?
.PNG?w=350&fit=crop&auto=format)
A 34-year-old woman presents with a small tumor mass in the right breast. After a biopsy is obtained, what is your diagnosis?
A 43-year-old man presents with abdominal pain and diarrhea, and a gastric biopsy is obtained. What is your diagnosis?
.PNG?w=350&fit=crop&auto=format)
A 47-year-old man presents with a lesion in the right tibia. After further assessment, a biopsy is performed. What is your diagnosis?

A 34-year-old man presents with a dermal lesion, and a biopsy is performed. What is your diagnosis?